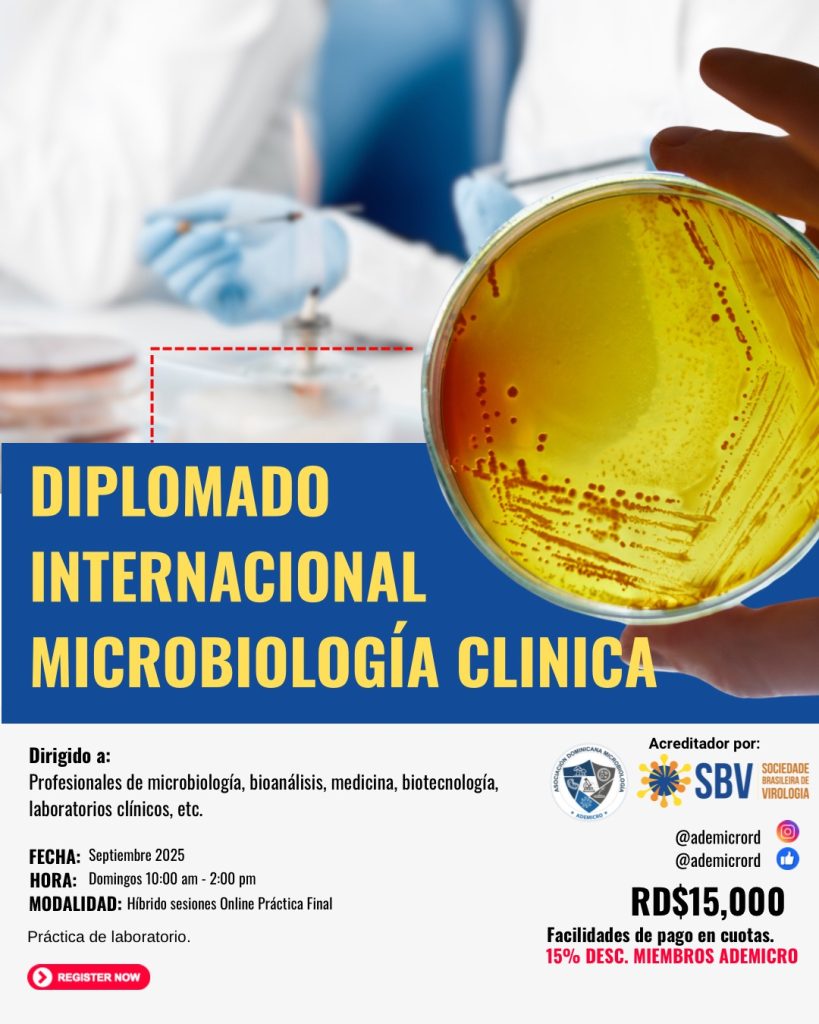

La Asociación Dominicana de Microbiología (ADEMICRO) Inc., comprometida con la formación continua y el fortalecimiento profesional del gremio microbiológico, se honra en anunciar la realización del 1er Diplomado Internacional en Microbiología Clínica, programado para iniciar en el mes de septiembre de 2025.
Este programa de formación especializada tiene como objetivo actualizar y profundizar los conocimientos de los profesionales de la microbiología clínica, integrando enfoques innovadores en el diagnóstico microbiológico, control de calidad, gestión de laboratorios y vigilancia de infecciones, con el respaldo de expertos nacionales e internacionales.
El diplomado contará con el aval académico de reconocidas instituciones y la participación de docentes de trayectoria en el ámbito clínico y científico.
Próximamente se estarán publicando más detalles sobre el contenido programático, modalidad, proceso de inscripción y requisitos de participación a través de website www.ademicrord.com
La asociación invita a todos los profesionales y estudiantes avanzados del área a mantenerse atentos a sus redes y canales oficiales para formar parte de esta histórica primera edición.




























